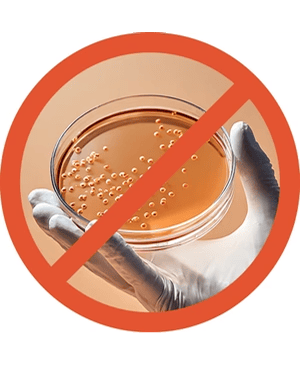

All Products
OUR PROMISE
QUALITY WITHOUT COMPROMISE
MOLECULAR ABSORPTION TECH
Next-generation fiber science engineered for ultimate reliability and comfort.
VETTED BY SCIENCE
Third-party lab tested for PFAS and harmful chemicals. Purely clinical, purely Femttoss.
OUR EDITORIAL JOURNAL
In-depth explorations into hormonal health, minimalist living, and planetary impact.
READ JOURNALMeet The Team Behind Femttoss
It all began when three men noticed the women in their families struggling during their periods, unable to step out due to the lack of proper restrooms and safe disposal options. Realizing this was a widespread issue, they set out to find a better solution.
Driven by empathy, they envisioned a world where intimate wellness was no longer a barrier to a woman’s freedom. This led to the birth of Femttoss—a brand dedicated to redefining comfort through innovative and sustainable technology. By blending thoughtful design with body-safe materials, they created solutions that allow women to move through their daily lives with total confidence and care.